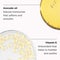
Thumbnail Image

Number 1 Wellbeing & Healthcare Platform
Get 40% off on 1st online pharmacy purchase Use Code: NEW40
Online Pharmacy/Beauty & Personal Care/Skin Care/Lip Care
/Image Ormedic Balancing Lip Enhancement Complex Lip Balm 7g
10% Off
Image Ormedic Balancing Lip Enhancement Complex Lip Balm 7g
AED 122.85
AED 136.50
(All prices include VAT)
123 Pts
Free delivery by Tomorrow


100% Secure Payment

Genuine Brands
Overview
Overview
- Lip treatment that deeply moisturises for instant comfort and softness
- Enriched with avocado oil and vitamin E
- Instant comfort leaves lips soft and fuller-looking
- Polypeptide complex supports natural firmness and volume
- Non sticky formula
Benefits
Benefits
- Provides antioxidant care to support daily protection
- Enables smoother, plumper lips with consistent hydration
- Maintains moisture balance for a supple lip texture
- Ensures lasting softness by soothing dryness instantly
- Delivers fuller appearance with firming peptide action
How to Use
How to Use
- Apply to clean lips morning and evening
- Add after skincare routine for ideal results
- Reapply during the day whenever needed
- Layer over lip colour to enhance shine
- Maintain consistent use for ongoing lip comfort
Description
Description
Designed for those seeking hydration and smoothness without harsh ingredients, Image Ormedic Balancing Lip Enhancement Complex is a trusted daily essential. Its luxurious, glossy texture not only comforts but also enhances the lips’ appearance, leaving them soft, supple, and naturally plump. This nourishing treatment delivers deep moisture and visible fullness to the lips while maintaining a natural, healthy look. At the heart of the formula lies a nourishing blend of avocado oil and vitamin E. Avocado oil, rich in essential fatty acids and natural emollients, replenishes lost moisture and softens lips, easing dryness and flakiness. Vitamin E acts as a potent antioxidant that protects against environmental stressors while soothing irritation. Together, they maintain the delicate balance required for healthy, hydrated lips. A key feature of the Image Ormedic Balancing Lip Enhancement Complex 7 g is the polypeptide complex infused with palmitoyl tripeptide-5, which supports lip firmness and fullness over time.
Specifications
Specifications
Brand
Image
Gender
Unisex
Life Stage
Adults
Form
Balm
Application
Lips
Weight (gram)
7
Storage Temperature
Cool Temperature
Country of Origin
USA
Legal Disclaimer